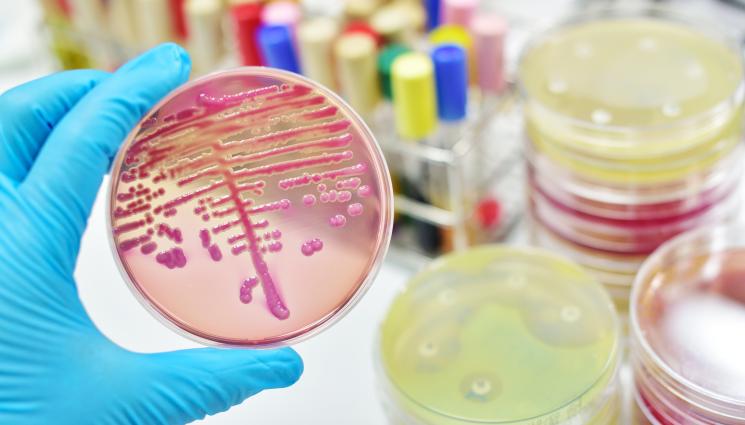
гъбички - СЗО АЛАРМИРА: Вид гъбична инфекция се оказа заплаха за човечеството!

С ветовната здравна организация официално обяви гъбичната инфекция за „заплаха за човечеството“, тъй като почти невидимият убиец отнема живота на един на всеки трима заразени пациенти.
След инцидент в Обединените арабски емирства, при който инфекцията засегна мозъка на мъж, Световната здравна организация (СЗО) публикува сериозно предупреждение за инфекцията с Candida auris (C. auris). Според докладите им, инфекцията се разпространява в болниците и може да бъде резистентна към лекарства и лечения, предоставяни от тези заведения, пише New York Post.
Инфекцията е открита през 2009 г., след като се е появила в ушния канал на 70-годишна японка. Оттогава е свързана с няколко смъртни случая по света. Данните сочат, че един на всеки трима души, заразени с инфекцията, умира от нея. С тревожни съобщения за лекарствена резистентност, СЗО предупреди пациентите да бъдат бдителни.
Гъбичките могат да оцелеят върху болнични повърхности в продължение на седмици и често са устойчиви на дезинфектанти и лекарства. Веднъж попаднали в организма, те могат да се разпространят в кръвта, мозъка, гръбначния мозък, костите, корема, ушите, белите дробове и пикочната система.
Според Центровете за контрол и превенция на заболяванията в САЩ, C. auris е „вид дрожди, които не се виждат с просто око. Под микроскоп клетките на C. auris изглеждат като малки, овални структури, обикновено с размер около 2,5-5 микрометра“.
Що се отнася до симптомите, те зависят от местоположението и тежестта на инфекцията. Често срещаните признаци обаче включват треска, втрисане и изтощение.
В екстремни случаи, C. auris може да причини инфекции на кръвта, рани w ушите и дихателните пътища.
Съвсем наскоро 34-годишен мъж разви инфекцията, след като беше приет в болница три месеца по-рано за травматично мозъчно нараняване при автомобилна катастрофа.
От ОАЕ пациентът е откаран в болница „Сакр“ в Рас ал-Хайма и е приет в интензивно отделение с кървене от устата, няколко порязвания и тежко разкъсване на скалпа. В допълнение към това, той е имал няколко мозъчни кръвоизлива.
Той прекара два месеца в интензивно отделение, подлагайки се на антибиотично лечение. На 99-ия си ден обаче претърпя друга операция за отстраняване на излишната течност от мозъка му. Там откриха, че има инфекция с C. Auris.
За щастие за него, лекарите му дали триседмични противогъбични инжекции, две лекарства чрез интравенозна система в продължение на 15 дни и след това 11-дневен курс от противогъбични таблетки. Кръвните изследвания в крайна сметка се показали без резултати, но пациентът прекарал седем месеца в болница след първоначалния си инцидент.
Лекарите му написаха в Journal of Medical Case Reports: „Прекомерната употреба на противогъбични средства в селското стопанство и здравеопазването е допринесла за развитието на противогъбична резистентност при C. аuris“.